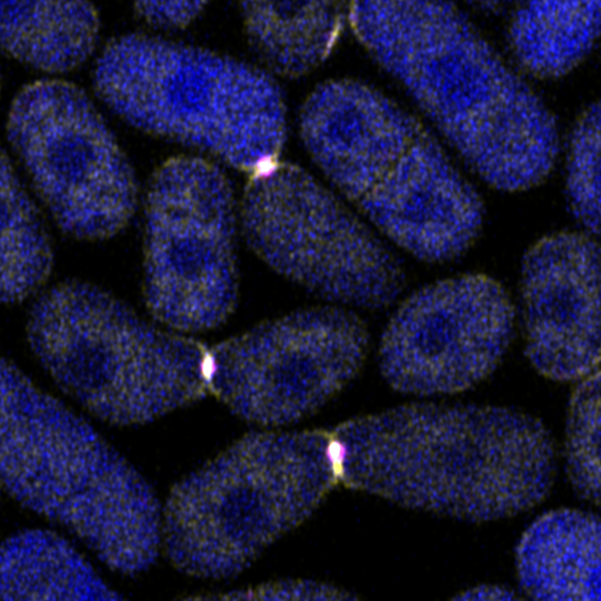

Orianne Foussadier: 1st Prize of the Jury at UNIGE’s MT180 competition
Latest News
Upcoming seminars
Plant Science Seminar (BIVEG internal seminar)
Christophe Buser
Lopez Molina lab
Internal Seminar
A50A,
Sciences III
Host: Roman Ulm
Geneva Plant Seminars
Alan Pacheco
UNIL
Discovery and modulation of metabolic interactions among plant-associated bacteria
1S059,
Sciences III
Host: Theresa Fitzpatrick
Plant Science Seminar (BIVEG internal seminar)
Fabio Miloro
Lopez Molina lab
Internal Seminar
A50A,
Sciences III
Host: Roman Ulm
Dpt of Plant Sciences
Johannes Rötzer
Gregor Mendel Institute of Molecular Plant Biology
Light-directed growth orientation in Marchantia polymorpha
1S059,
Sciences III
Host: Roman Ulm